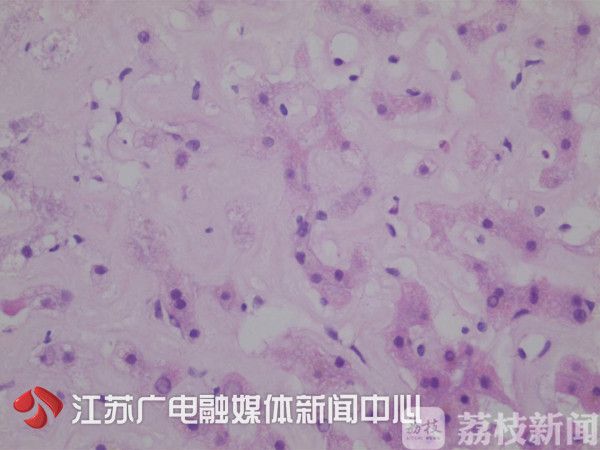

荔枝新闻讯 市民李先生不到一年时间,体重减了三分之一,从180斤闪电瘦到了120斤!不过,李先生却没有开心多久,紧接着出现蛋白尿、鼻腔出血、消化不良……最终,他被确诊患上一种罕见病:淀粉样变性。
这是一种什么病呢?哪些暴瘦要小心?

一年不到暴瘦60斤 异常症状接踵而至

李先生今年50岁,去年年初,他还是个180斤的胖子,不到一年时间,体重骤减到了120斤。暴瘦之后,本以为更健康,可结果却出现了淋巴结肿大的现象,又是活检,又是鼻腔镜检查,都没有查出毛病。而李先生的病情却在持续恶化,接连出现心慌、消化不良、蛋白尿,还发生了三次鼻腔大出血。南京市第二医院肝病内科主任熊清芳说:"当时我们平常用的乳胶漆的大桶,整整装满了两桶的止血卫生纸。"李先生的家人也表示:"觉得身体有问题,所以就去医院查,但是有查不出来问题,全家都很着急。"
确诊淀粉样变性 发病率为10万分之4.5
因为每次发病,都伴有肝功能异常,最终通过肝部活检,李先生被确诊患上一种致命的罕见病:淀粉样变性。这种病的发生率仅为10万分之4.5,非常少见,它是由于血液中的一种淀粉样蛋白出现异常,无法代谢,沉积在脏器上,累积到一定程度后,导致患者多器官功能受损而死亡。
医生说,淀粉样变性的发病原因很多,遗传、淋巴瘤、结核、糖尿病,都可能致病。熊清芳说:"发病有不同原因,预后也是不一样的,有文献报道,通过化疗,活到七八年的也有,而活到一两年的也有。"
目前,李先生还在治疗中。医生提醒,淀粉样变性,一般发生于40岁以上人群,除了不明原因暴瘦外,舌头变大、皮肤大面积长斑、四肢水肿、全身多脏器同时出现问题,都是征兆。一旦出现这些症状,要尽早进行活检确诊。
按照目前临床来看,肿瘤、甲亢、糖尿病等,都会导致身体出现暴瘦。那除了正常的减肥之外,如果身体出现了异常暴瘦,并伴随有一些指标异常,市民就要高度重视并做相应检查。
(来源:江苏广电融媒体新闻中心/汪乐萍 编辑/国正)
相关知识
突然暴瘦会得什么病
5岁男孩暴瘦成“纸片人”,医生对照上百罕见病终确诊,全球报道仅200例
有什么病是突然暴瘦的
突然不明原因暴瘦,经检查,竟是癌症来临?
21岁姑娘暴瘦30斤结果悔惨!糖尿病为何会让你瘦成闪电?
有什么疾病是突然暴瘦的
减肥不能心急,突然暴瘦的危害比你想象中的要多!
减肥暴瘦却减出了糖尿病
突然变瘦竟是这种恶疾前兆
闪电瘦腿 快速减肥A计划
网址: 闪电瘦竟然是罕见病!有些“暴瘦”你得小心 https://m.trfsz.com/newsview159359.html